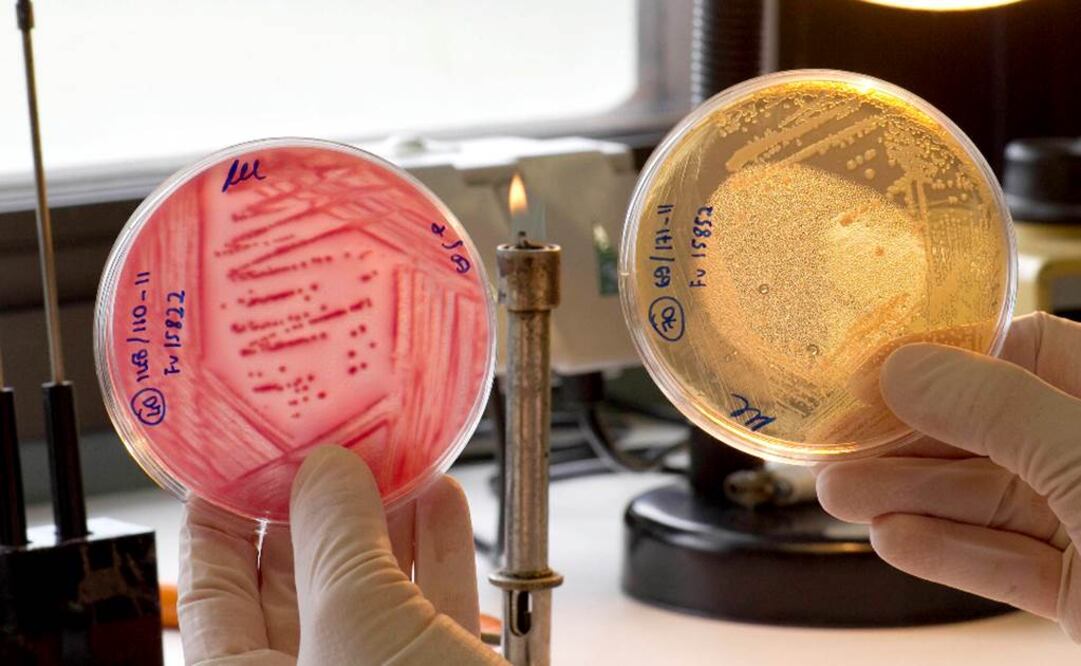
Abre una vía para nuevas investigaciones. Foto: Archivo

Científicos británicos han hallado en el océano un grupo bacteriano que parece desempeñar un papel relevante en la regulación del clima de la Tierra, según divulga este lunes la revista Nature Microbiology en su último número.
El estudio encontró que el grupo Pelagibacterales, que se incluye entre los organismos más abundantes del planeta, tiene una función destacada a la hora de estabilizar la atmósfera.
Ese grupo está formado por hasta medio millón de células microbiales halladas en fragmentos de agua del mar, equivalentes en tamaño a una cuchara pequeña.
Ben Temperton, profesor del departamento de Biociencia de la Universidad de Exeter (Inglaterra), fue uno de los integrantes del equipo internacional de investigadores que por primera vez identificó al citado grupo de Pelagibacterales como origen probable de la producción del compuesto químico de sulfato de dimetilo (DMS).
Ese DMS estimula la formación de las nubes, y es una sustancia fundamental en la llamada "hipótesis de Claw", según la cual algunos organismos del fitoplancton contribuyen a la producción de sulfato de dimetilo, que posteriormente regulará la formación de las nubes.
A través de varios procesos químicos, el DMS incrementa unas partículas esféricas de agua, formadas por la condensación de vapor de agua, que reducen a su vez la cantidad de la luz del sol que se proyecta sobre la superficie oceánica.
Los últimos hallazgos revelan la relevancia de los Pelagibacterales en este proceso y abre una vía para nuevas investigaciones.
"Este trabajo muestra que los Pelagibacterales constituyen un compuesto importante en la estabilidad climática. Si vamos a mejorar los modelos de cómo el DMS impacta en el clima, necesitamos considerar este organismo como un contribuyente principal", dijo Temperton.
Este experto destacó que lo que resulta "fascinante" es "la elegancia y la simplicidad de la producción del DMS en los Pelagibacterales".
kal
Noticias según tus intereses
[Publicidad]
[Publicidad]